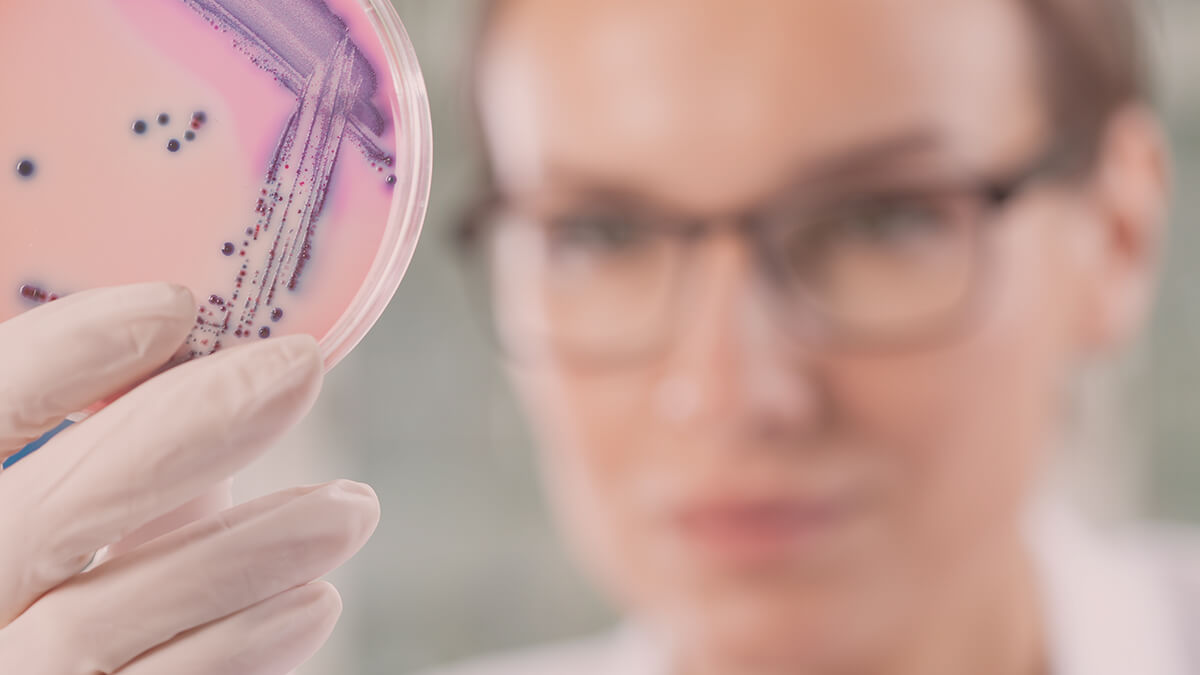

- Health
- Immune Health
- The Science
Real Talk about CFUs – How Many Do You Actually Need?
If you have ever taken a probiotic before, it is no doubt that your bottle mentioned the term “CFUs.” CFUs, or colony-forming units, tell you how many good bacteria or yeast...
1 min read
If you have ever taken a probiotic before, it is no doubt that your bottle mentioned the term “CFUs.” To give you an example, think about your vitamin supplements. Just like those, probiotics each have a certain dose of bacteria in their contents. These are called CFUs, or colony-forming units. The number on your bottle actually tells you how many good bacteria or yeast you will receive from it. And these bacteria are able to divide and form colonies.

At any time, each of us has about 100 trillion bacteria living in our bodies. That is why having more of the good ones is very important for our health. So, if probiotic bacteria can colonize our bodies, that means they are alive and active. As a result, they can help restore the balance in your gut. In menopause, this is very important. That is because gut health was linked to many symptoms like hot flashes, mood swings, brain fog, and low sex drive, among others.
How Many CFUs Do You Really Need?
The answer to this question mainly depends on the reason why you want to start taking probiotics in the first place. If you’re going to use them to support your immune system and overall health, 5-20 billion CFUs per day will be a good number to start. For people who use probiotics to treat a specific mild illness or symptom, these doses can go up to 30 billion. And if you have a significant health concern and want to use probiotics as a supplementary therapy, it is best to speak to your doctor.
Products with 50-100 billion CFUs are becoming more and more popular these days. But does more necessarily mean better for you? A study on probiotics and diarrhea has shown that for acute infection, higher doses were more effective short term. For chronic conditions, on the other hand, more extended periods of treatment were more helpful than merely increasing the dose.
The goal of the probiotics is to bring gut microflora into balance. And people who want to take the pills just for overall health benefits do not need a lot of good bacteria colonies to restore that balance. Instead of getting a high dose supplement, it is better to just take probiotics over a more prolonged period. If you are taking antibiotics, then a higher dose of probiotics over a longer period is better since your gut flora will be under a lot of stress from the meds.
How to Store Those CFUs
Some probiotics might have as low as 100 million live bacteria, while others can list the amounts reaching trillions. So as we can see, there is much variety in the types and the dosages. But there is also a variety in their storage. Probiotic foods are usually kept in the refrigerator because the good bacteria are sensitive to moisture and heat. Heat can kill good bacteria. This means that any food you buy off the shelf outside the fridge most likely does not have probiotics.

When it comes to supplements, though, pills usually have bacteria that were freeze-dried and packaged. It helps prevent heat and moisture from getting to them. In that case, you do not have to keep them in the fridge. But still, try not to expose them to heat above room temperature. Now that we have that clear let’s talk more about the dosage. Do you know how many CFUs is enough?
Food vs. Supplement
Dairy products are perhaps the most well-known and widely used probiotic foods. Their role in the prevention and treatment of bowel disorders is already shown to be helpful, but they also have the potential to help with other diseases. Apart from that, people prefer eating probiotic foods over taking supplements, but it was found that both are effective in delivering good bacteria to our bodies.
So, can you eat enough probiotic foods that you do not need a supplement? Probably not, because they are not going to become the main staple in your daily meals, but rather a small addition to them. Apart from that, some people do not like the taste or the smell of probiotic-rich foods. If one of these reasons applies to you, using a supplement will become a safe and effective way to get more good bacteria into your body.
Single Strain or Multi-Strain?
Some probiotics offer just one strain of bacteria, while others contain several strains in one supplement. Single strain probiotics usually address a particular problem, be it a symptom of menopause like hot flashes, or a disease like irritable bowel syndrome (IBD). When you look for those, it is best to check recent studies on the effects of probiotics on your particular disease or symptom.
You might still be uncertain about what strain to use after reading studies. But if you want to find relief from a problem like IBS, diarrhea, weight gain, colitis, or vaginal infections, speak to your doctor about probiotic advice. When it comes to more severe issues, probiotics might work as an additional therapy rather than a treatment in itself.

When you choose multi-strain probiotics for your symptoms, you get a similar effect to probiotics which you get from foods. In case you do not eat probiotic foods regularly, such a supplement will be your best option. For general health and immune system support, a multi-strain probiotic works great. But make sure you get the one that contains probiotics from both Lactobacillus and Bifidobacterium families.
Related Products
Blend Besties Bundle
Fresh Start Bundle
4.7 / 5.0
(550) 550 total reviews